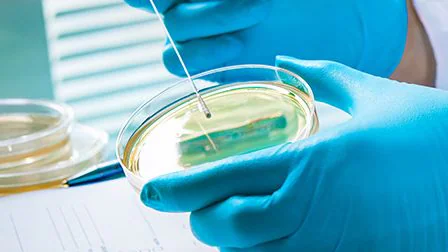
Culture testing in lab setting Culture testing in lab setting

What to know
In the United States, the management of emerging and zoonotic infectious diseases is controlled by a combination of state and federal laws.
Background
Emerging infectious diseases are infections that have increased recently or are threatening to increase in the near future. These infections could be—
- Completely new (like Bourbon virus, which was discovered in 2014 in Kansas, or MERS, Middle East Respiratory Syndrome)
- Completely new to an area (like chikungunya in Florida)
- Reappearing in an area (like dengue in south Florida and Texas)
- Caused by bacteria that have become resistant to antibiotics, like MRSA (methicillin-resistant Staphylococcus aureus), C. difficile, or drug-resistant tuberculo
Zoonotic infectious diseases are spread from animals to humans by ticks, mosquitoes, fleas, or contact with animals; examples include—
- Lyme disease (spread by ticks)
- Salmonella (spread by poultry)
- Rabies (spread by mammals)
Additional information
The resources below evaluate and explain selected emerging and zoonotic infectious disease laws:
- Raw Milk: Map of State Laws Related to the Sale of Unpasteurized Milk | This map shows state laws governing the sale of unpasteurized milk to consumers as of May 2019. It also shows changes to state laws that expanded or restricted access to unpasteurized milk from 2012 through 2018.
- Raw Milk: A Research Anthology of Legal and Public Health Resources | Raw milk, or milk that has not been pasteurized, is a public health concern. The consumption of raw milk is linked to a significant number of foodborne illnesses and studies have shown that the legal sale of unpasteurized dairy products is associated with a higher incidence of related disease outbreaks. In recent years, consumer demand has resulted in expanded legal access to raw milk in several states. This anthology provides resources that describe and discuss some of the legal and public health issues associated with the sale of raw milk.
- State Rabies Vaccination Laws for Domestic Dogs, Cats, and Ferrets in the United States | Rabies is a fatal virus that attacks the central nervous system. It is most commonly transmitted when a rabid animal bites another animal or a person. Without prophylactic measures, the infection will result in death within days of onset. This LawAtlas map, created by CDC's Public Health Law Program, includes data on state-level pre-exposure rabies vaccination laws for domestic dogs, cats, and ferrets across the United States. It also includes data on those laws referencing the Compendium of Animal Rabies Prevention and Control[PDF – 259KB], which contains the most current rabies vaccination recommendations. This dataset relies on external validation for accuracy and understanding of the application of laws and policies.
- State Laws Requiring Hand Sanitation Stations at Animal Contact Exhibits — United States, March-April, 2016[PDF – 178KB] | Disease transmission linked to petting zoos, agricultural fairs, and other animal contact exhibits continues to be a public health threat in the United States and can be avoided by proper hand washing after contact with animals. Some states have used the law as a public health intervention to reduce disease outbreaks associated with animal contact exhibits. This article summarizes the results of a 50-state legal assessment that collected and analyzed state statutes and regulations requiring hand sanitation stations at animal contact exhibits. [Hoss A, Basler C, Stevenson L, Gambino-Shirley K, Park Robyn M, Nichols M. State laws requiring hand sanitation stations at animal contact exhibits. United States, March-April 2016. MMWR 2017;66:16-18.]
- Menu of State Hand Sanitation Laws for Animal Contact Exhibits[PDF – 554KB] | Animals at petting zoos and agricultural fairs can be carriers of pathogens, such as Escherichia coli. Disease outbreaks at animal contact exhibits can be prevented by handwashing after contact with animals and keeping food and beverage away from exhibits. This menu assesses and provides examples of state animal contact exhibit hand sanitation laws.
- Menu of State Turtle-Associated Salmonellosis Laws[PDF – 1MB] | Turtles are often carriers of salmonella, which can cause serious salmonellosis infections in humans, particularly among vulnerable populations such as young children and the elderly. In recent years, salmonellosis outbreaks linked to pet turtles have increased throughout the United States. This menu addresses state and territorial laws regarding the sale of turtles, as well as other laws that limit turtle use and distribution.
Learn more about emerging and zoonotic diseases by visiting CDC's National Center for Emerging and Zoonotic Infectious Diseases.